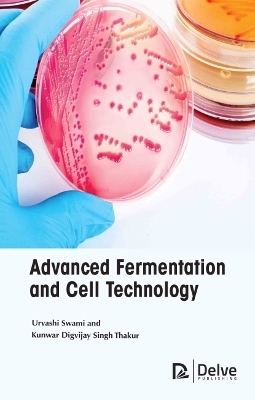
Advanced Fermentation and Cell Technology - Urvashi Swami and Kunwar Digvijay Singh Thakur, Kunwar Digvijay Singh Thakur

Advanced Fermentation and Cell Technology
Seiten
2021
Delve Publishing (Verlag)
9781774691007 (ISBN)
Delve Publishing (Verlag)
9781774691007 (ISBN)
- Titel nicht im Sortiment
- Artikel merken
Presents a collection of comprehensive information on technological advancements that have been developed by bridging the fermentation technology and cytology. The book presents details concerning the various laboratory and industrial applications of plant, mammalian-microbial cell systems to process and formulate advanced bio-products.
The present book is a collection of comprehensive information on technological advancements that have been developed by bridging the fermentation technology and cytology. It exhibits details concerning the various laboratory and industrial applications of plant, mammalian & microbial cell systems to process and formulate advanced bio-products such as enzymes, beverages, single cell proteins, pharmaceuticals, cosmetics, etc. Advanced fermentation and cell technology offers practical insights and references for microbiologists, bio-engineers and researchers to delve deeper into industry-oriented techniques and applications involving biological systems to upgrade contemporary practices of formulating bio-based industrial products.
The present book is a collection of comprehensive information on technological advancements that have been developed by bridging the fermentation technology and cytology. It exhibits details concerning the various laboratory and industrial applications of plant, mammalian & microbial cell systems to process and formulate advanced bio-products such as enzymes, beverages, single cell proteins, pharmaceuticals, cosmetics, etc. Advanced fermentation and cell technology offers practical insights and references for microbiologists, bio-engineers and researchers to delve deeper into industry-oriented techniques and applications involving biological systems to upgrade contemporary practices of formulating bio-based industrial products.
Chapter 1 Introduction to Fermentation and Cell Technology
Chapter 2 Microorganisms in the Fermentation Process
Chapter 3 Fermentation Miniaturization
Chapter 4 Aerobic and Anaerobic Solid-Phase Fermentation
Chapter 5 Scaling-Up of Industrial Microbial Processes
Chapter 6 Dietary Uses of Microbial Fermentation
Chapter 7 Role of Microbial Fermentation in Food Quality Enhancement
Chapter 8 Medical Applications of Industrial Fermentation
| Erscheinungsdatum | 11.04.2022 |
|---|---|
| Sprache | englisch |
| Maße | 152 x 229 mm |
| Gewicht | 653 g |
| Themenwelt | Naturwissenschaften ► Biologie ► Biochemie |
| Naturwissenschaften ► Biologie ► Zellbiologie | |
| Technik ► Umwelttechnik / Biotechnologie | |
| ISBN-13 | 9781774691007 / 9781774691007 |
| Zustand | Neuware |
| Informationen gemäß Produktsicherheitsverordnung (GPSR) | |
| Haben Sie eine Frage zum Produkt? |
Mehr entdecken
aus dem Bereich
aus dem Bereich


